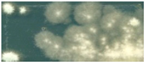

Protection of Historical Wood against Microbial Degradation—Selection and Application of Microbiocides
Abstract
:1. Introduction
- Selection of active biocidal substances against the microflora isolated from historical wood at the former Auschwitz II-Birkenau concentration and extermination camp;
- Selection of biocides containing the selected active compounds;
- Checking the activity and assessing the effectiveness of the biocides against microbes colonizing the wood surface;
- Protecting the wood samples from further contamination with microorganisms, under laboratory and in situ conditions;
- Evaluating the impact of biocides on new and historical wood colour and luminance;
- Developing a procedure for the protection of historical buildings from biodeterioration.
2. Results
2.1. Active Compounds
2.2. Biocides
2.3. The Activity of Biocides against Microorganisms Colonizing the Wood Surface
2.4. Protection of Wood Samples from the Development of Microorganisms: Laboratory Tests
2.5. Protection of Historical Wood Samples from the Development of Microorganisms—In Situ Tests
2.6. Evaluation of Changes in the Colour and Luminance of Wood after Application of the Tested Disinfectants
3. Discussion
4. Materials and Methods
4.1. Microorganisms
4.2. Determining the Minimum Inhibitory Concentrations of Active Compounds in Biocides
4.3. Determining the Antimicrobial Activity of Biocides by Disc Diffusion Method
4.4. New and Historical Wood
4.5. Activity of Biocides against Microorganisms Colonizing Wood Surface
4.6. Protecting New Wood Samples against Microorganism Growth: Laboratory Tests
4.7. Protecting Historical Wood Samples against Microorganism Growth—In Situ Tests
4.8. The Evaluation Scale for the Antimicrobial Activity of the Biocides Applied to the New and Historical Wood Surfaces
4.9. The Impact of Biocides on the Wood Colour
- L—luminance ranging from 0 (black) to 100 (white).
- a—the scope from red to green.
- b—the scope from yellow to blue.
5. Conclusions
Acknowledgments
Author Contributions
Conflicts of Interest
References
- Blanchette, R.A. A review of microbial deterioration found in archeological wood from different environments. Int. Biodeterior. Biodegrd. 2000, 46, 189–204. [Google Scholar] [CrossRef]
- Unger, A.; Schniewind, A.P.; Unger, W. Conservation of wood artifacts; Springer-Verlag: Berlin, Germany, 2001. [Google Scholar]
- Irbe, I.; Karadelev, M.; Andersone, I.; Andersons, B. Biodeterioration of external wooden structures of the Latvian cultural heritage. J. Cult. Herit. 2012, 13, S79–S84. [Google Scholar] [CrossRef]
- Sterflinger, K.; Piñar, G. Microbial deterioration of cultural heritage and works of art—Tilting at windmills? Appl. Microbiol. Biotechnol. 2013, 97, 9637–9646. [Google Scholar] [CrossRef] [PubMed]
- Daniel, G.F.; Nilsson, T.; Singh, A.P. Degradation of lignocellulosis by unique tunnel-forming bacteria. Can. J. Microb. 1987, 33, 943–948. [Google Scholar] [CrossRef]
- Gaylarde, C.C.; Morton, L.H.G. Deteriogenic biofilms on buildings and their control: A review. Biofouling 1999, 14, 59–74. [Google Scholar] [CrossRef]
- Fazio, A.T.; Papinutti, L.; Gomez, B.A.; Parera, S. D.; Rodríguez Romero, A.; Siracusano, G.; Maier, M.S. Fungal deterioration of a Jesuit South American polychrome wood sculpture. Int. Biodeterior. Biodegrd. 2010, 64, 694–701. [Google Scholar] [CrossRef]
- Susi, P.; Aktuganov, G.; Himanen, J.; Korpela, T. Biological control of wood decay against fungal infection. J. Environ. Manag. 2011, 92, 1681–1689. [Google Scholar] [CrossRef] [PubMed]
- Reinprecht, L. Fungicides for wood protection—World viewpoint and evaluation/testing in Slovakia. In Fungicides; Carisse, O., Ed.; InTech: Rijeka, Croatia, 2010; pp. 95–122. [Google Scholar]
- Schultz, T.P.; Nicholas, D.D.; Preston, A.F. A brief review of the past, present and future of wood preservation. Pest. Manag. Sci. 2007, 63, 784–788. [Google Scholar] [CrossRef] [PubMed]
- Salminen, E.; Valo, R.; Korhonen, M.; Jernlås, R. Wood Preservation with Chemicals. Best Available Techniques (BAT); Nordic Council of Ministers: Copenhagen, Denmark, 2014. [Google Scholar]
- Fojutowski, A.; Szukala, R.; Pernak, J. The Effect of an Ionic Liquid of Imidazolium Tetrafluoroborates Series on Scots Pine Wood Properties; International Research Group on Wood Protection: Stockholm, Sweden, 2007. [Google Scholar]
- Coleman, R.D.; Clausen, C.A. Multifactorial Antimicrobial Wood Protectants; The International Research Group on Wood Protection: Stockholm, Sweden, 2008. [Google Scholar]
- Zabielska-Matejuk, J.; Stangierska, A.; Kot, M. New ammonium-and 1,2,4-triazolium-based ionic liquids for wood preservation. J. Wood Chem. Technol. 2015, 35, 178–192. [Google Scholar] [CrossRef]
- Paulus, W. Part Two—Microbicide data. In Directory of Microbiocides for the Protection of Materials a Handbook; Paulus, W., Ed.; Springer: Dordrecht, The Netherlands, 2004; pp. 444–773. [Google Scholar]
- Regulation (EU) no 528/2012 of the European Parliament and of the Council of 22 May 2012 Concerning the Making Available on the Market and Use of Biocidal Products. Available online: http://eur-lex.europa.eu/LexUriServ/LexUriServ.do?uri=OJ:L:2012:167:0001:0123:en:PDF (accessed on 24 July 2016).
- Wörlea, M.; Hubert, V.; Hildbrand, E.; Hunger, K.; Lehmann, E.; Mayer, I.; Petrak, G.; Pracher, M.; von Arx, U.; Wülfert, S. Evaluation of decontamination methods of pesticide contaminated wooden objects in museum collections: Efficiency of the treatments and influence on the wooden structure. J. Cult. Herit. 2012, 13, S209–S215. [Google Scholar] [CrossRef]
- Koziróg, A.; Otlewska, A.; Piotrowska, M.; Rajkowska, K.; Nowicka-Krawczyk, P.; Hachułka, M.; Wolski, G.J.; Gutarowska, B.; Kunicka-Styczyńska, A.; Libudzisz, Z.; et al. Colonising organisms as a biodegradation factor affecting historical wood materials at the former concentration camp of Auschwitz II-Birkenau. Int. Biodeterior. Biodegrd. 2014, 86, 171–178. [Google Scholar] [CrossRef]
- Register of Biocidal Products, Part I Containing a List of BIOCIDAL Products Which Have Been Granted a Marketing Authorization. Available online: http://bip.urpl.gov.pl/pl/biuletyny-i-wykazy/produkty-biob%C3%B3jcze (accessed on 9 May 2016).
- Mokrzycki, W.; Tatol, M. Color difference Delta E—A survey. MGV 2011, 20, 383–411. [Google Scholar]
- Clausen, C.A.; Yang, V. Protecting wood from mould, decay, and termites with multi-component biocide systems. Int. Biodeterior. Biodegrd. 2007, 59, 20–24. [Google Scholar] [CrossRef]
- Rajkowska, K.; Koziróg, A.; Otlewska, A.; Piotrowska, M.; Nowicka-Krawczyk, P.; Brycki, B.; Kunicka-Styczyńska, A.; Gutarowska, B. Quaternary ammonium biocides as antimicrobial agents protecting historical wood and brick. Acta Biochim. Pol. 2016, 63, 153–159. [Google Scholar] [CrossRef] [PubMed]
- Obanda, D.N.; Shupe, T.F.; Barnes, H.M. Reducing leaching of boron-based wood preservatives—A review of research. Bioresour. Technol. 2008, 99, 7312–7322. [Google Scholar] [CrossRef] [PubMed]
- Young, M.E.; Alakomi, H.L.; Fortune, I.; Gorbushina, A.A.; Krumbein, W.E.; Maxwell, I.; McCullagh, C.; Robertson, P.; Saarela, M.; Valero, J.; et al. Development of a biocidal treatment regime to inhibit biological growths on cultural heritage: BIODAM. Environ. Geol. 2008, 56, 631–641. [Google Scholar] [CrossRef]
- Aydin, I.; Colakoglu, G. Effects of surface inactivation, high temperature drying and preservative treatment on surface roughness and colour of alder and beech wood. Appl. Surf. Sci. 2005, 252, 430–440. [Google Scholar] [CrossRef]
- Tomak, E.D.; Viitanen, H.; Yildiz, U.C.; Hughes, M. The combined effects of boron and oil heat treatment on the properties of beech and scots pine wood. Part 2: Water absorption, compression strength, color changes, and decay resistance. J. Mater. Sci. 2011, 46, 608–615. [Google Scholar] [CrossRef]
- Ozgenc, O.; Yildiz, U.C. Surface characteristics of wood treated with new generation preservatives after artificial weathering. Wood Res. 2014, 59, 605–616. [Google Scholar]
- Hunt, D. Properties of wood in the conservation of historical wooden artifacts. J. Cult. Herit. 2012, 13S, S10–S15. [Google Scholar] [CrossRef]
- Piotrowska, M.; Otlewska, A.; Rajkowska, K.; Koziróg, A.; Hachułka, M.; Nowicka-Krawczyk, P.; Wolski, G.J.; Gutarowska, B.; Kunicka-Styczyńska, A.; Żydzik-Białek, A. Abiotic Determinants of the historical buildings biodeterioration in the former Auschwitz II-Birkenau concentration and extermination camp. PLoS ONE 2014, 9, e109402. [Google Scholar] [CrossRef] [PubMed]
- Gutarowska, B.; Celikkol-Aydin, S.; Bonifay, V.; Otlewska, A.; Aydin, E.; Oldham, A.L.; Brauer, J.I.; Duncan, K.E.; Adamiak, J.; Sunner, J.A.; et al. Metabolomic and high-throughput sequencing analysis—modern approach for the assessment of biodeterioration of materials from historic buildings. Front. Microbiol. 2015, 6, 979. [Google Scholar] [CrossRef] [PubMed]
- Gutarowska, B.; Żakowska, Z. Elaboration and application of mathematical model for estimation of mouldcontamination of some building materials based on ergosterol content determination. Int. Biodeterior. Biodegrd. 2002, 49, 299–305. [Google Scholar] [CrossRef]
- Fojutowski, A.; Koziróg, A.; Kropacz, A.; Noskowiak, A. The susceptibility of some acetylated hardwood species to mould fungi attack—An attempt to objectify the assessment. Int. Biodeterior. Biodegrd. 2014, 86, 60–65. [Google Scholar] [CrossRef]
- Temiz, A.; Yildiz, U.C.; Aydin, I.; Eikenes, M.; Alfredsen, G.; Çolakoglu, G. Surface roughness and color characteristics of wood treated with preservatives after accelerated weathering test. Appl. Surf. Sci. 2005, 250, 35–42. [Google Scholar] [CrossRef]






| Microorganism | Compound | ||||||
|---|---|---|---|---|---|---|---|
| DDAC | APDA | HP | GA | SH | BA | LA | |
| Bacillus cereus KM036070.1 | 0.02 | 0.02 | 2 | 2 | 0.2 | 5 | 4 |
| Pseudomonas fluorescens KM036083.1 | 7 | 0.02 | 2 | 2 | 0.2 | 2 | 4 |
| Staphylococcus equorum KM036089.1 | 0.02 | 0.02 | 2 | 2 | 0.2 | 8 | 4 |
| Alternaria alternate ŁOCK 0594 | 0.2 | 0.2 | 2 | 2 | 2 | 2 | >10 |
| Cladosporium cladosporioides ŁOCK 0592 | 0.2 | 0.2 | 2 | 4 | 0.2 | 12 | >10 |
| Engyodontium album ŁOCK 0590 | 0.2 | 0.2 | 0.2 | 0.2 | 0.02 | 8 | 10 |
| Penicillium citreonigrum ŁOCK 0597 | 2 | 2 | 2 | 0.2 | 2 | 2 | >10 |
| Cheatomium globosum ŁOCK 0591 | 0.2 | 0.2 | 0.2 | 2 | 7 | 2 | >10 |
| Microorganisms | Biocide | |||||||
|---|---|---|---|---|---|---|---|---|
| ABM-1 | ABM-2 | A LV 706 | AT | B | M | P R80 | R101 | |
| Bacteria | 1 | 1 | 10 | 1 | 15 | 10 | 2.5 | 1 |
| Moulds | 6 | 6 | 10 | 6 | 20 | 20 | 6 | 6 |
| Application | Biocide | New Material | Historical Material | ||
|---|---|---|---|---|---|
| ΔE | ΔL | ΔE | ΔL | ||
| Spraying | Boramon | 0.44 ± 0.31 a,A | −0.43 ± 0.19 a,B | 0.23 ± 0.06 a,A | −0.07 ± 0.02 a,C |
| Rocima 101 | 0.45 ± 0.21 a,A | −0.42 ± 0.28 a,b,B | 0.78 ± 0.33 b,A | −0.63 ± 0.13 b,C | |
| Fogging | ABM-1 | 0.49 ± 0.29 a,A | −0.15 ± 0.02 b,C | 1.38 ± 0.34 b,B | −1.38 ± 0.25 c,D |
| Rocima 101 | 0.48 ± 0.23 a,A | −0.33 ± 0.17 a,b,C | 2.82 ± 0.99 c,B | −1.81 ± 0.53 c,D | |
| Compound | Acronym | Concentration Used in the Tests (% v/v) |
|---|---|---|
| Didecyldimethylammonium Chloride | DDAC | 12, 10, 7, 3, 2, 0.2, 0.02 |
| N-(3-aminopropyl)-N-dodecylpropane-1,3-diamine | APDA | 5, 2, 0.5, 0.2, 0.02 |
| Hydrogen Peroxide | HP | 15, 10, 7, 5, 2, 0.2, 0.02 |
| Glutaraldehyde | GA | 10, 5, 4, 2, 0.2, 0.02 |
| Sodium Hypochlorite | SH | 7, 5, 2, 0.2, 0.02 |
| Boric Acid | BA | 12, 8, 5, 2, 0.2, 0.02 |
| l-lactic Acid | LA | 10, 8, 4, 2, 0.2 |
| Biocide | Active Components | Concentrations (% v/v) |
|---|---|---|
| ABM-1 (MDA Sp. z o.o., Poland) | N-3-aminopropyl-N-alkyl(C10-C14)-1,3-propanediamine N,N-dialkyl(C10-C16)-N-methyl-N-poly(oxyethylene)ammonium propionate N,N-dialkyl(C10-C14)-N,N-dimethyl ammonium chloride 2-[3-(dodecanoylamino)]propyl dimethyl ammonium acetate | 1, 2, 4, 6, 8 |
| ABM-2 (MDA Sp. z o.o., Poland) | N-3-aminopropyl-N-alkyl(C10-C14)-1,3-propanediamine N,N-dialkyl(C10-C16)-N-methyl-N-poly(oxyethylene)ammonium propionate N,N-dialkyl(C10-C14)-N,N-dimethyl ammonium chloride | 1, 2, 4, 6, 8 |
| Acticide LV 706 (THOR GmbH, Germany) | 2.5%–10% (v/v) (benzyl alkyl(C8–18) dimethylammonium chlorides 2.5%–10% (v/v) diethylene glycol <2.5% (v/v) 2-octyl-2H-isothiazole-3-one | 10, 15, 20 |
| Atoxyn (Polfa S.A., Poland) | 10% (v/v) benzyl alkyl (C8–18)dimethylammonium bromides | 1, 2.5, 6, 8, 12 |
| Boramon (Altax Sp. z o.o., Poland) | 24% (v/v) benzyl alkyl(C12–16)dimethylammonium chlorides 5% (v/v) boric acid | 10, 15, 20, 30 |
| Mycetox B’ (ADW Sp. z o.o., Poland) | <9.5% (v/v) N,N-didecyl-N,N-dimethylammonium chloride 2% (v/v) citric acid; 0.5% (v/v) (2-metoksymetyloetoksy)propanol | 10, 20, 30 |
| Preventol R80 (Bayer AG, Germany) | 80% (v/v) benzyl alkyl dimethylammonium chloride 8%–12% (v/v) (2-methoxymethylethoxy)propanol | 2.5, 6, 12 |
| Rocima 101 (H.S.H. Sp. z o.o., Poland) | 40%–<60% (v/v) N,N-didecyl-N,N-dimethylammonium chloride 20%–<25% (v/v) isopropanol | 0.5, 1, 2, 6, 8 |
| Biocidal Activity | Bacteria | Reduction in the Number of Bacteria | Moulds | % of the Surface Contamination of Samples |
|---|---|---|---|---|
| High 5 | ![]() | 8 log | ![]() | no growth |
| Good 4 | ![]() | 6 log | ![]() | 25% |
| Low 3 | ![]() | 4 log | ![]() | 50% |
| Very Low 2 | ![]() | 2 log | ![]() | 75% |
| No Activity 1 | ![]() | no reduction | ![]() | 100% |
© 2016 by the authors; licensee MDPI, Basel, Switzerland. This article is an open access article distributed under the terms and conditions of the Creative Commons Attribution (CC-BY) license (http://creativecommons.org/licenses/by/4.0/).
Share and Cite
Koziróg, A.; Rajkowska, K.; Otlewska, A.; Piotrowska, M.; Kunicka-Styczyńska, A.; Brycki, B.; Nowicka-Krawczyk, P.; Kościelniak, M.; Gutarowska, B. Protection of Historical Wood against Microbial Degradation—Selection and Application of Microbiocides. Int. J. Mol. Sci. 2016, 17, 1364. https://doi.org/10.3390/ijms17081364
Koziróg A, Rajkowska K, Otlewska A, Piotrowska M, Kunicka-Styczyńska A, Brycki B, Nowicka-Krawczyk P, Kościelniak M, Gutarowska B. Protection of Historical Wood against Microbial Degradation—Selection and Application of Microbiocides. International Journal of Molecular Sciences. 2016; 17(8):1364. https://doi.org/10.3390/ijms17081364
Chicago/Turabian StyleKoziróg, Anna, Katarzyna Rajkowska, Anna Otlewska, Małgorzata Piotrowska, Alina Kunicka-Styczyńska, Bogumił Brycki, Paulina Nowicka-Krawczyk, Marta Kościelniak, and Beata Gutarowska. 2016. "Protection of Historical Wood against Microbial Degradation—Selection and Application of Microbiocides" International Journal of Molecular Sciences 17, no. 8: 1364. https://doi.org/10.3390/ijms17081364
APA StyleKoziróg, A., Rajkowska, K., Otlewska, A., Piotrowska, M., Kunicka-Styczyńska, A., Brycki, B., Nowicka-Krawczyk, P., Kościelniak, M., & Gutarowska, B. (2016). Protection of Historical Wood against Microbial Degradation—Selection and Application of Microbiocides. International Journal of Molecular Sciences, 17(8), 1364. https://doi.org/10.3390/ijms17081364